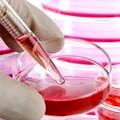
Küçük resim

OECD Sağlık Verileri: Türkiye’deki hemşirelerin %76’sı yurt dışında çalışmak istiyor
Ekonomik Kalkınma ve İşbirliği Örgütü (OECD) Sağlık Verileri 2022’ye göre, Türkiye 100 bin nüfusa düşen toplam hemşire sayısında 43 ülke...
DevamıProf. Dr. Paşa Göktaş wrote a new post, Yaza girerken bocavirus infeksiyonlarında belirgin artış görülüyor 9 yıl 12 ay önce
 Yaza girerken bocavirus infeksiyonlarında belirgin artış görülüyorGüncel verilere göre, yaz aylarına girdiğimiz son dönemde, Bocavirus Tip-1 infeksiyonlarında belirgin bir artış gözlenmektedir. Gelişim Tıp Laboratuvarları’na, mültipleks PCR yöntemiyle solunum yolu mikrobik etkenlerini belirlemek istemiyle 2016 Nisan’da 53, Mayıs’ta…
Yaza girerken bocavirus infeksiyonlarında belirgin artış görülüyorGüncel verilere göre, yaz aylarına girdiğimiz son dönemde, Bocavirus Tip-1 infeksiyonlarında belirgin bir artış gözlenmektedir. Gelişim Tıp Laboratuvarları’na, mültipleks PCR yöntemiyle solunum yolu mikrobik etkenlerini belirlemek istemiyle 2016 Nisan’da 53, Mayıs’ta…
Prof. Dr. Paşa Göktaş wrote a new post, DSÖ, Türkiye’yi de Zika virüsü için riskli ülkeler arasında ilan etti 10 yıl önce
 DSÖ, Türkiye’yi de Zika virüsü için riskli ülkeler arasında ilan ettiDSÖ, önlem alınmaması durumunda Aedes sivrisineklerinin 18 ülkede virüsü yayabileceğini açıkladı. Bu 18 ülke, en yüksek riskten düşüğe doğru şöyle sıralanıyor: Fransa, İtalya, Malta, Hırvatistan, İsrail, İspanya, Monako, San Marino, Türkiye, Yunanistan…
DSÖ, Türkiye’yi de Zika virüsü için riskli ülkeler arasında ilan ettiDSÖ, önlem alınmaması durumunda Aedes sivrisineklerinin 18 ülkede virüsü yayabileceğini açıkladı. Bu 18 ülke, en yüksek riskten düşüğe doğru şöyle sıralanıyor: Fransa, İtalya, Malta, Hırvatistan, İsrail, İspanya, Monako, San Marino, Türkiye, Yunanistan…
Prof. Dr. Paşa Göktaş wrote a new post, Üniversite hastanelerinin trajikomik durumu ağırlaşarak devam ediyor 10 yıl 2 ay önce
 Üniversite hastanelerinin trajikomik durumu ağırlaşarak devam ediyorÜniversite hastanelerinin çoğu, fiilen iflas durumundadırlar. Bir kısmı, halen 2012 ve 2013 yılında aldıkları malların bedelini ödeyememiş durumdadırlar. Birçok firma ile icralık-mahkemelik haldedirler. Prof. Dr. Paşa Göktaş, mevcut durumu analiz etti.
Üniversite hastanelerinin trajikomik durumu ağırlaşarak devam ediyorÜniversite hastanelerinin çoğu, fiilen iflas durumundadırlar. Bir kısmı, halen 2012 ve 2013 yılında aldıkları malların bedelini ödeyememiş durumdadırlar. Birçok firma ile icralık-mahkemelik haldedirler. Prof. Dr. Paşa Göktaş, mevcut durumu analiz etti.
Prof. Dr. Paşa Göktaş wrote a new post, Türkiye’nin sağlık sorunları ne tür bir sağlık bakanını gerekli kılıyor? 10 yıl 7 ay önce
 Türkiye’nin sağlık sorunları ne tür bir sağlık bakanını gerekli kılıyor?Türkiye’nin sağlık sorunları nelerdir? Bazılarına göre, Türkiye’nin sağlık sorunları oldukça azdır ve büyük ölçüde çözülmüş durumdadır. Ama gerçekler hiç de öyle değildir. Türkiye’nin, oldukça boyutlu ve derin sağlık sorunları bulunmaktadır. Bunları özetle…
Türkiye’nin sağlık sorunları ne tür bir sağlık bakanını gerekli kılıyor?Türkiye’nin sağlık sorunları nelerdir? Bazılarına göre, Türkiye’nin sağlık sorunları oldukça azdır ve büyük ölçüde çözülmüş durumdadır. Ama gerçekler hiç de öyle değildir. Türkiye’nin, oldukça boyutlu ve derin sağlık sorunları bulunmaktadır. Bunları özetle…
Prof. Dr. Paşa Göktaş wrote a new post, Sağlık Bakanlığı ile Üniversite Hastaneleri arasındaki protokol, sorunu çözmez! 10 yıl 9 ay önce
 Sağlık Bakanlığı ile Üniversite Hastaneleri arasındaki protokol, sorunu çözmez!Birkaç gün önce, Sağlık Bakanı ile YÖK Başkanı arasında, üniversite hastanelerinin malzeme sorununu çözmek üzere bir protokol imzalandığı belirtildi. Bu protokol, sorunu çözmez. Neden çözmez? Prof. Dr. Paşa Göktaş, konunun tüm detaylarını analiz eden bir yazı kaleme aldı.
Sağlık Bakanlığı ile Üniversite Hastaneleri arasındaki protokol, sorunu çözmez!Birkaç gün önce, Sağlık Bakanı ile YÖK Başkanı arasında, üniversite hastanelerinin malzeme sorununu çözmek üzere bir protokol imzalandığı belirtildi. Bu protokol, sorunu çözmez. Neden çözmez? Prof. Dr. Paşa Göktaş, konunun tüm detaylarını analiz eden bir yazı kaleme aldı.
Prof. Dr. Paşa Göktaş wrote a new post, Cerrahpaşa batıyor-muş! 10 yıl 10 ay önce
 Cerrahpaşa batıyor-muş!Günaydın beyler. İstanbul Üniversitesi Cerrahpaşa Tıp Fakültesi Hastaneleri batıyormuş. Yakında iflasını açıklayacakmış. Sadece Cerrahpaşa Değil, Tüm Üniversite Hastaneleri Böyle! Sadece Cerrahpaşa mı? Çapa da böyle. Hacettepe de böyle, Gazi Üniversitesi Tıp Fakültesi Hastaneleri de böyle.
Cerrahpaşa batıyor-muş!Günaydın beyler. İstanbul Üniversitesi Cerrahpaşa Tıp Fakültesi Hastaneleri batıyormuş. Yakında iflasını açıklayacakmış. Sadece Cerrahpaşa Değil, Tüm Üniversite Hastaneleri Böyle! Sadece Cerrahpaşa mı? Çapa da böyle. Hacettepe de böyle, Gazi Üniversitesi Tıp Fakültesi Hastaneleri de böyle.
Prof. Dr. Paşa Göktaş wrote a new post, Domuz gribi vakalarının sayısı artıyor! Paniğe gerek var mı? 11 yıl 3 ay önce
 Domuz gribi vakalarının sayısı artıyor! Paniğe gerek var mı?Gelişim Tıp Laboratuvarları’na gelen hasta örnekleri üzerinde yapılan çalışmalara göre, “Domuz Gribi” adıyla bilinen Influenza A H1N1 vakalarının sayısında artış görülmektedir. 2014 yılının son üç ayında gelen 164 vaka incelenmesinde hiç H1N1 vakası tespit edilmemişti.
Domuz gribi vakalarının sayısı artıyor! Paniğe gerek var mı?Gelişim Tıp Laboratuvarları’na gelen hasta örnekleri üzerinde yapılan çalışmalara göre, “Domuz Gribi” adıyla bilinen Influenza A H1N1 vakalarının sayısında artış görülmektedir. 2014 yılının son üç ayında gelen 164 vaka incelenmesinde hiç H1N1 vakası tespit edilmemişti.
Prof. Dr. Paşa Göktaş wrote a new post, Hastanelerdeki yığılmaya karşı SGK ayaktan sağlık kuruluşları ile sözleşme yapmalı 11 yıl 5 ay önce
 Hastanelerdeki yığılmaya karşı SGK ayaktan sağlık kuruluşları ile sözleşme yapmalıAklın Yolu Birdir! Hastanelerdeki Yığılmaları Azaltmaya Yönelik Arayışlar Var! Basında yer alan haberlere göre, hastanelerdeki ve […]
Hastanelerdeki yığılmaya karşı SGK ayaktan sağlık kuruluşları ile sözleşme yapmalıAklın Yolu Birdir! Hastanelerdeki Yığılmaları Azaltmaya Yönelik Arayışlar Var! Basında yer alan haberlere göre, hastanelerdeki ve […]
Prof. Dr. Paşa Göktaş wrote a new post, Yeni TTB asgari ücret tarifesi TTB-HUV hakkında 11 yıl 5 ay önce
 Yeni TTB asgari ücret tarifesi TTB-HUV hakkındaTürk Tabipleri Birliği (TTB), yeni hazırlamış olduğu ve daha önceleri TTB Asgari Ücret Tarifesi adıyla anılan, hekimlik uygulamalarına ait işlem listesini, TTB-HUV […]
Yeni TTB asgari ücret tarifesi TTB-HUV hakkındaTürk Tabipleri Birliği (TTB), yeni hazırlamış olduğu ve daha önceleri TTB Asgari Ücret Tarifesi adıyla anılan, hekimlik uygulamalarına ait işlem listesini, TTB-HUV […]
Prof. Dr. Paşa Göktaş wrote a new post, Üniversite hastanelerinin Sağlık Bakanlığı’na devri çözüm olabilir mi? 12 yıl önce
 Üniversite hastanelerinin Sağlık Bakanlığı’na devri çözüm olabilir mi?Basında, üniversite hastanelerinin yakında çıkarılacak bir yasayla fiilen Sağlık Bakanlığı’na devredileceği yazılıyor. Konunun akademik yönü […]
Üniversite hastanelerinin Sağlık Bakanlığı’na devri çözüm olabilir mi?Basında, üniversite hastanelerinin yakında çıkarılacak bir yasayla fiilen Sağlık Bakanlığı’na devredileceği yazılıyor. Konunun akademik yönü […]
Prof. Dr. Paşa Göktaş wrote a new post, Üniversite hastanelerinin iflasa sürüklenmesinin nedenleri… 12 yıl 4 ay önce
 Üniversite hastanelerinin iflasa sürüklenmesinin nedenleri…Üniversite hastanelerinin iflasa sürüklenmesinin nedenleri hakkında bir yazı kaleme alan Prof. Dr. Paşa Göktaş, mevcut durumun çıkmaza girmesinin nedenleri ve sorunların çözüm yolları hakkında önemli analizlerde bulunarak hükümet yetkililerine sesleniyor.
Üniversite hastanelerinin iflasa sürüklenmesinin nedenleri…Üniversite hastanelerinin iflasa sürüklenmesinin nedenleri hakkında bir yazı kaleme alan Prof. Dr. Paşa Göktaş, mevcut durumun çıkmaza girmesinin nedenleri ve sorunların çözüm yolları hakkında önemli analizlerde bulunarak hükümet yetkililerine sesleniyor.
Prof. Dr. Paşa Göktaş wrote a new post, Sağlık sisteminin temel sorunları sürüyor 12 yıl 4 ay önce
 Sağlık sisteminin temel sorunları sürüyorSağlık sisteminin temel sorunlarının artarak devam ettiğini belirten yazarımız Prof. Dr. Paşa Göktaş, yaşanan sorunları ana başlıklar halinde okurlarımız için analiz ederek […]
Sağlık sisteminin temel sorunları sürüyorSağlık sisteminin temel sorunlarının artarak devam ettiğini belirten yazarımız Prof. Dr. Paşa Göktaş, yaşanan sorunları ana başlıklar halinde okurlarımız için analiz ederek […]
Prof. Dr. Paşa Göktaş wrote a new post, Laboratuvar testlerinin de bir maliyeti var! 12 yıl 7 ay önce
Laboratuvar testlerinin de bir maliyeti var!Evet, laboratuvar testlerinin de bir maliyeti bulunuyor. Hem de öyle az bir maliyet değil. Çünkü, tıpta en pahalı ürün teknoloji ve bilgidir. Laboratuvar testleri de bu […]
Laboratuvar testlerinin de bir maliyeti var!Evet, laboratuvar testlerinin de bir maliyeti bulunuyor. Hem de öyle az bir maliyet değil. Çünkü, tıpta en pahalı ürün teknoloji ve bilgidir. Laboratuvar testleri de bu […]
Prof. Dr. Paşa Göktaş profil fotoğrafını değiştirdi 12 yıl 7 ay önce
Prof. Dr. Paşa Göktaş kayıtlı bir üye oldu 12 yıl 7 ay önce